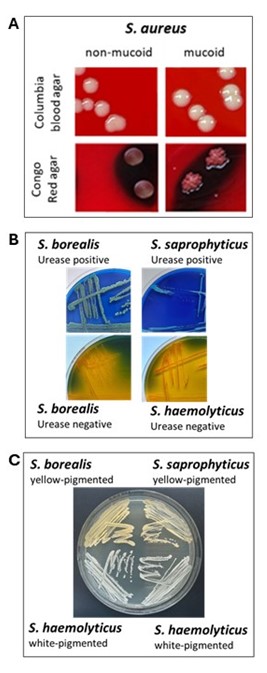

Infection-related microbiology
Coagulase-positive staphylococci (CPS) such as S. aureus and S. argenteus cause infections ranging from superficial wound and soft tissue infections to severe systemic infections such as sepsis. Both species also play a significant role as colonisers and pathogens of the lungs, especially in people with cystic fibrosis. In respiratory samples from these individuals, mucoid isolates can be detected that, due to acquired mutations, are capable of forming biofilms. These biofilms protect the bacteria, for example, from immune cells and antibiotics. In collaboration with the research group of Prof. B. Kahl, we have already identified several mechanisms involved in the formation of polysaccharide-based biofilms; the elucidation of further mechanisms is the subject of ongoing investigations.
Coagulase-negative staphylococci (CoNS) such as S. haemolyticus are part of the commensal skin and mucosal flora but can also cause device-associated infections. In contrast to those of CoPS, their biofilms consist mainly of proteins and extracellular DNA. The genes and proteins involved have so far not sufficiently characterised and are a current focus of our research. Moreover, some atypical S. haemolyticus isolates appear to exhibit virulence factors typically found in S. aureus. Current studies aim to determine which factors these are and whether they contribute to increased pathogenicity of these atypical isolates.
A particular focus of our research group lies on a recently discovered CoNS species and the question of whether it could represent a previously undiscovered uropathogen. Clinical data suggest that S. borealis may occur both as a commensal and as a pathogen of the urogenital tract, particularly in older males. Research is currently underway to determine whether certain characteristics of S. borealis, such as urease production and the formation of a yellow pigment, make it more pathogenic than the closely related species S. haemolyticus.